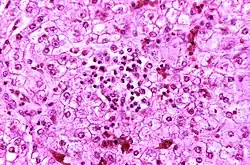

Reye syndrome
| Reye syndrome | |
|---|---|
| Other names | Reye's syndrome |
![]() | |
| Appearance of a liver from a child who died of Reye syndrome as seen with a microscope. Hepatocytes are pale-staining due to intracellular fat droplets. | |
| Pronunciation |
|
| Specialty | Pediatrics |
| Symptoms | Vomiting, personality changes, confusion, seizures, loss of consciousness[1] |
| Complications | Persistent vegetative state, coma |
| Causes | Unknown[2] |
| Risk factors | Aspirin use in children, viral infection[1][2] |
| Treatment | Supportive care[1] |
| Medication | Mannitol[2] |
| Prognosis | 1/3 long term disability[2][3] |
| Frequency | Less than one in a million children a year[2] |
| Deaths | ~30% chance of death[2][3] |
Reye syndrome is a rapidly worsening brain disease.[2] Symptoms of Reye syndrome may include vomiting, personality changes, confusion, seizures, and loss of consciousness.[1] While liver toxicity typically occurs in the syndrome, jaundice usually does not.[2] Death occurs in 20–40% of those affected with Reye syndrome, and about a third of those who survive are left with a significant degree of brain damage.[2][3]
The cause of Reye syndrome is unknown.[2] It usually begins shortly after recovery from a viral infection, such as influenza or chickenpox.[1] About 90% of cases in children are associated with aspirin (salicylate) use.[2] Inborn errors of metabolism are also a risk factor.[3] The syndrome is associated with changes on blood tests such as a high blood ammonia level, low blood sugar level, and prolonged prothrombin time.[2] Often, the liver is enlarged in those who have the syndrome.[2]
Prevention is typically by avoiding the use of aspirin in children.[1] When aspirin was withdrawn for use in children in the US and UK in the 1980s, a decrease of more than 90% in rates of Reye syndrome was observed.[2] Early diagnosis of the syndrome improves outcomes.[1] Treatment is supportive;[1] mannitol may be used to help with the brain swelling.[2]
The first detailed description of Reye syndrome was in 1963 by Australian pathologist Douglas Reye.[4] The syndrome most commonly affects children.[2] It affects fewer than one in a million children a year.[2] The general recommendation to use aspirin in children was withdrawn because of Reye syndrome, with use only recommended in Kawasaki disease.[3]
Signs and symptoms
Reye syndrome progresses through five stages:[5][6][7][8]
- Stage I
- Vasoconstrictive rash on palms of hands and feet
- Persistent, heavy vomiting that is not relieved by not eating
- Generalized lethargy
- Confusion
- Nightmares (possible symptom)
- No fever usually present[9]
- Headaches
- Stage II
- Deep lethargy
- Delirium
- Confusion
- Combative behavior
- Stupor
- Hyperventilation
- Fatty liver (found on biopsy)
- Hyperactive reflexes
- Stage III
- Continuation of Stage I and II symptoms
- Possible coma
- Possible cerebral edema
- Possible seizures
- Rarely, respiratory arrest
- Decorticate posturing
- Stage IV
- Seizures
- Decerebrate posturing
- Deepening coma
- Dilated pupils with minimal response to light
- Loss of oculocephalic reflexes
- Minimal but still present liver dysfunction
- Stage V
- Very rapid onset following stage IV
- Areflexia
- Deep coma
- Dilated, nonreactive pupils
- Isoelectric EEG
- Respiratory arrest
- Seizures
- Multiple organ failure[10]
- Flaccidity
- Hyperammonemia (above 300 mg/dL of blood)
- Death
Causes
The cause of Reye syndrome is unknown.[2] It usually begins shortly after recovery from a viral infection, such as influenza or chickenpox.[1] About 90% of cases in children are associated with aspirin (salicylate) use.[2] Inborn errors of metabolism are also a risk factor.[3]
The association with aspirin has been shown through epidemiological studies. The diagnosis of Reye syndrome greatly decreased in the 1980s, when genetic testing for inborn errors of metabolism was becoming available in industrialized countries.[11] A retrospective study of 49 survivors of cases diagnosed as Reye syndrome showed that the majority of the surviving patients had various metabolic disorders, particularly a fatty-acid oxidation disorder medium-chain acyl-CoA dehydrogenase deficiency.[12]
Aspirin
There is an association between taking aspirin for viral illnesses and the development of Reye syndrome,[13] but no animal model of Reye syndrome has been developed in which aspirin causes the condition.[11]
The serious symptoms of Reye syndrome appear to result from damage to cellular mitochondria,[14] at least in the liver, and there are a number of ways that aspirin could cause or exacerbate mitochondrial damage. A potential increased risk of developing Reye syndrome is one of the main reasons that aspirin has not been recommended for use in children and teenagers, the age group for which the risk of lasting serious effects is highest.[15]
In some countries, oral mouthcare product Bonjela (not the form specifically designed for teething) has labeling cautioning against its use in children, given its salicylate content. There have been no cases of Reye syndrome following its use, and the measure is a precaution.[16] Other medications containing salicylates are often similarly labeled as a precaution.[17]
The Centers for Disease Control and Prevention (CDC), the U.S. Surgeon General, the American Academy of Pediatrics (AAP) and the Food and Drug Administration (FDA) recommend that aspirin and combination products containing aspirin not be given to children and teenagers under 19 years of age during episodes of fever-causing illnesses. Hence, in the United States, it is advised that the opinion of a doctor or pharmacist should be obtained before anyone under 19 years of age is given any medication containing aspirin (also known on some medicine labels as acetylsalicylate, salicylate, acetylsalicylic acid, ASA, or salicylic acid).[18]
Current advice in the United Kingdom by the Committee on Safety of Medicines is that aspirin should not be given to those under the age of 16 years, unless specifically indicated in Kawasaki disease or in the prevention of blood clot formation.[19]
Diagnosis
Differential diagnosis
Causes for similar symptoms include
- Various inborn metabolic disorders
- Viral encephalitis
- Drug overdose or poisoning
- Head trauma
- Liver failure due to other causes
- Meningitis
- Kidney failure
- Shaken baby syndrome
Treatment
Treatment is supportive.[1] Mannitol may be used to help with the brain swelling.[2]
Prognosis
Documented cases of Reye syndrome in adults are rare. The recovery of adults with the syndrome is generally complete, with liver and brain function returning to normal within two weeks of onset.
In children, mild to moderate to severe permanent brain damage is possible, especially in infants. Over thirty percent of the cases reported in the United States from 1981 through 1997 resulted in fatality.[20]
Epidemiology
Reye syndrome occurs almost exclusively in children. While a few adult cases have been reported over the years, these cases do not typically show permanent neural or liver damage. Unlike in the United Kingdom, the surveillance for Reye syndrome in the United States is focused on people under 18 years of age.
In 1980, after the CDC began cautioning physicians and parents about the association between Reye syndrome and the use of salicylates in children with chickenpox or virus-like illnesses, the incidence of Reye syndrome in the United States began to decline, prior to the FDA's issue of warning labels on aspirin in 1986.[11] In the United States between 1980 and 1997, the number of reported cases of Reye syndrome decreased from 555 cases in 1980 to about two cases per year since 1994. During this time period 93% of reported cases for which racial data were available occurred in whites and the median age was six years. In 93% of cases a viral illness had occurred in the preceding three-week period. For the period 1991–1994, the annual rate of hospitalization due to Reye syndrome in the United States was estimated to be between < 0.3 – 1 per million population less than 18 years of age.[21]
During the 1980s, a case-control study carried out in the United Kingdom also demonstrated an association between Reye syndrome and aspirin exposure.[22] In June 1986, the United Kingdom Committee on Safety of Medicines issued warnings against the use of aspirin in children under 12 years of age and warning labels on aspirin-containing medications were introduced. United Kingdom surveillance for Reye syndrome documented a decline in the incidence of the illness after 1986. The reported incidence rate of Reye syndrome decreased from a high of 0.63 per 100,000 population less than 12 years of age in 1983–1984 to 0.11 in 1990–1991.
From November 1995 to November 1996 in France, a national survey of pediatric departments for children under 15 years of age with unexplained encephalopathy and a threefold (or greater) increase in serum aminotransferase and/or ammonia led to the identification of nine definite cases of Reye syndrome (0.79 cases per million children). Eight of the nine children with Reye syndrome were found to have been exposed to aspirin. In part because of this survey result, the French Medicines Agency reinforced the international attention to the relationship between aspirin and Reye syndrome by issuing its own public and professional warnings about this relationship.[23]
History
The syndrome is named after Douglas Reye, who, along with fellow physicians Graeme Morgan and Jim Baral, published the first study of the syndrome in 1963 in The Lancet.[24] In retrospect, the occurrence of the syndrome may have first been reported in 1929. Also in 1964, George Johnson and colleagues published an investigation of an outbreak of influenza B that described 16 children who developed neurological problems, four of whom had a profile remarkably similar to Reye syndrome. Some investigators refer to this disorder as Reye-Johnson syndrome, although it is more commonly called Reye syndrome. In 1979, Karen Starko and colleagues conducted a case-control study in Phoenix, Arizona, and found the first statistically significant link between aspirin use and Reye syndrome.[25] Studies in Ohio and Michigan soon confirmed her findings[26] pointing to the use of aspirin during an upper respiratory tract or chickenpox infection as a possible trigger of the syndrome. Beginning in 1980, the CDC cautioned physicians and parents about the association between Reye syndrome and the use of salicylates in children and teenagers with chickenpox or virus-like illnesses. In 1982, the U.S. Surgeon General issued an advisory, and in 1986, the Food and Drug Administration required a Reye syndrome-related warning label for all aspirin-containing medications.[27]
References
- ^ a b c d e f g h i j "NINDS Reye's Syndrome Information Page". NINDS. September 25, 2009. Archived from the original on August 1, 2016. Retrieved August 8, 2016.
- ^ a b c d e f g h i j k l m n o p q r s t Pugliese, A; Beltramo, T; Torre, D (October 2008). "Reye's and Reye's-like syndromes". Cell Biochemistry and Function. 26 (7): 741–6. doi:10.1002/cbf.1465. PMID 18711704. S2CID 22361194.
- ^ a b c d e f Schrör, K (2007). "Aspirin and Reye syndrome: a review of the evidence". Paediatric Drugs. 9 (3): 195–204. doi:10.2165/00148581-200709030-00008. PMID 17523700. S2CID 58727745.
- ^ McMillan, Julia A.; Feigin, Ralph D.; DeAngelis, Catherine; Jones, M. Douglas (2006). Oski's Pediatrics: Principles & Practice. Philadelphia: Lippincott Williams & Wilkins. p. 2306. ISBN 9780781738941. Archived from the original on August 15, 2016.
- ^ Knight, J. (2009). "Reye's Syndrome". Healthy Child Care. 12 (4). Archived from the original on May 22, 2013.
- ^ Boldt, D.W. (February 2003). "Reye Syndrome". University of Hawaii John A. Burns School of Medicine. Archived from the original on March 6, 2013.
- ^ "What is Reye's Syndrome?". National Reye's Syndrome Foundation. 1974. Archived from the original on May 11, 2013.
- ^ "Chapter XVIII.17. Reye Syndrome". Case Based Pediatrics for Medical Students and Residents. Retrieved February 18, 2023.
- ^ "Reye's Syndrome". KidsHealth.org. Nemour Foundation. Archived from the original on February 6, 2015. Retrieved February 6, 2015.
- ^ Ku AS, Chan LT (April 1999). "The first case of H5N1 avian influenza infection in a human with complications of adult respiratory distress syndrome and Reye's syndrome". Journal of Paediatrics and Child Health. 35 (2): 207–9. doi:10.1046/j.1440-1754.1999.t01-1-00329.x. PMID 10365363. S2CID 7985883.
- ^ a b c Orlowski JP, Hanhan UA, Fiallos MR (2002). "Is aspirin a cause of Reye's syndrome? A case against". Drug Safety. 25 (4): 225–31. doi:10.2165/00002018-200225040-00001. PMID 11994026. S2CID 20552758.
- ^ Orlowski JP (August 1999). "Whatever happened to Reye's syndrome? Did it ever really exist?". Critical Care Medicine. 27 (8): 1582–7. doi:10.1097/00003246-199908000-00032. PMID 10470768.
- ^ Hurwitz, E. S. (1989). "Reye's syndrome". Epidemiologic Reviews. 11: 249–253. doi:10.1093/oxfordjournals.epirev.a036043. PMID 2680560.
- ^ Gosalakkal JA, Kamoji V (September 2008). "Reye syndrome and reye-like syndrome". Pediatric Neurology. 39 (3): 198–200. doi:10.1016/j.pediatrneurol.2008.06.003. PMID 18725066.
- ^ Bennett, Charles L.; Starko, Karen M.; Thomsen, Henrik S.; Cowper, Shawn; Sartor, Oliver; Macdougall, Iain C.; Qureshi, Zaina P.; Bookstaver, P. Brandon; Miller, April D.; Norris, LeAnn B.; Xirasagar, Sudha; Trenery, Alyssa; Lopez, Isaac; Kahn, Adam; Murday, Alanna (December 2012). "Linking drugs to obscure illnesses: lessons from pure red cell aplasia, nephrogenic systemic fibrosis, and Reye's syndrome. a report from the Southern Network on Adverse Reactions (SONAR)". Journal of General Internal Medicine. 27 (12): 1697–1703. doi:10.1007/s11606-012-2098-1. ISSN 1525-1497. PMC 3509314. PMID 22692632.
- ^ "New advice on oral salicylate gels in under 16s" (Press release). Medicines and Healthcare products Regulatory Agency. April 23, 2009. Archived from the original on April 26, 2009. Retrieved May 1, 2009.
- ^ Grosser, T; Ricciotti, E (2023). "Pharmacotherapy of Inflammation, Fever, Pain, and Gout". In Brunton, LL; Knollmann, BC (eds.). Goodman & Gilman's: The Pharmacological Basis of Therapeutics (14th ed.). McGraw-Hill Education. ISBN 9781264258079. OCLC 1304471208.
- ^ "Reye Syndrome | NYP". NewYork-Presbyterian. Retrieved May 26, 2024.
- ^ "2.9 Antiplatelet drugs". British National Formulary for Children. British Medical Association and Royal Pharmaceutical Society of Great Britain. 2007. p. 151.
- ^ Belay, E. D.; Bresee, J. S.; Holman, R. C.; Khan, A. S.; Shahriari, A.; Schonberger, L. B. (May 6, 1999). "Reye's syndrome in the United States from 1981 through 1997". The New England Journal of Medicine. 340 (18): 1377–1382. doi:10.1056/NEJM199905063401801. ISSN 0028-4793. PMID 10228187.
- ^ Schrör, Karsten (2007). "Aspirin and Reye syndrome: a review of the evidence". Paediatric Drugs. 9 (3): 195–204. doi:10.2165/00148581-200709030-00008. ISSN 1174-5878. PMID 17523700.
- ^ Hall SM, Plaster PA, Glasgow JF, Hancock P (1988). "Preadmission antipyretics in Reye's syndrome". Arch. Dis. Child. 63 (7): 857–66. doi:10.1136/adc.63.7.857. PMC 1779086. PMID 3415311.
- ^ Autret-Leca E, Jonville-Béra AP, Llau ME, et al. (2001). "Incidence of Reye's syndrome in France: a hospital-based survey". Journal of Clinical Epidemiology. 54 (8): 857–62. doi:10.1016/S0895-4356(00)00366-8. PMID 11470397.
- ^ Reye RD, Morgan G, Baral J (1963). "Encephalopathy and fatty degeneration of the viscera. A Disease entity in childhood". Lancet. 2 (7311): 749–52. doi:10.1016/S0140-6736(63)90554-3. PMID 14055046.
- ^ Starko KM, Ray CG, Dominguez LB, Stromberg WL, Woodall DF (December 1980). "Reye's syndrome and salicylate use". Pediatrics. 66 (6): 859–864. doi:10.1542/peds.66.6.859. PMID 7454476. S2CID 41712701.
- ^ Mortimor, Edward A. Jr.; et al. (June 1, 1980). "Reye Syndrome-Ohio, Michigan". Morbidity and Mortality Weekly Report. 69 (29): 532, 810–2. PMID 7079050. Archived from the original on June 11, 2008.
- ^ "Aspirin Labels to Warn About Reye Syndrome". The New York Times. Associated Press. March 8, 1986. Archived from the original on March 5, 2016.
External links
- NINDS Reye's Syndrome Information Page Archived August 1, 2016, at the Wayback Machine